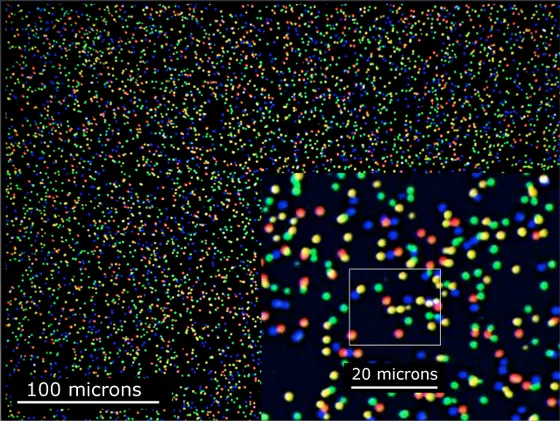
The latest methods in sequencing make even small genomic and epigenomic alterations in tumor cells visible.

Studying resistance of cancer cells
In the “MYC-NET" consortium, a team of researchers from DKFZ and Heidelberg University headed by Dr. Frank Westermann, Prof. Dr. Thomas Höfer and Dr. Stefan Pfister is investigating the molecular mechanisms that make cancer cells of pediatric brain tumors resistant to chemotherapy or radiotherapy. In many patients, these treatments cause mutations which help cancer cells to become resistant to therapy. In order to understand how these mutations impact the finely tuned balance between cell death and cell division, the group combines genetic, biochemical, systems-biological and mathematical approaches. In particular, they plan to observe under the microscope, for the first time, how cancer cells respond to chemotherapy in order to characterize the variability of cellular behavior and the selection of therapy-resistant cancer cells at individual cell level.
Packaging also plays a role
How can we treat one of the most frequent types of blood cancer in the Western world, chronic lymphocytic leukemia, more effectively? This question is being explored by scientists in the research network “CancerEpiSys".
The fact that cancer cells do not behave like normal cells is not only due to alterations in the genetic information as such, but also in its “packaging". Changes affecting the packaging can lead to the genetic information not being read correctly. As a result, an affected cell may turn off genes that normally prevent carcinogenesis. The research discipline that studies the manifold interactions of “packaging" and genetic information is called epigenetics. “We try to filter out epigenetic connections that are key to the development of and fight against chronic lymphocytic leukemia," said Dr. Karsten Rippe of the German Cancer Research Center and Dr. Daniel Mertens of the Department of Internal Medicine III of Ulm University Medicine, the coordinators of the new research network. At the same time, the researchers endeavor to find out how anticancer drugs with epigenetic working mechanisms influence these factors.
Optimum treatment of advanced lung cancer
In Germany, lung cancer is the most frequent cause of cancer-related death in men and the third most frequent in women. Most patients are treated by chemotherapy, which often leads to anemia as a side effect. Therefore, patients are frequently treated with a drug called erythropoietin (EPO) alongside chemotherapy; EPO promotes the formation of red blood cells, thus securing oxygen supply. However, in recent years researchers have found receptors for EPO on tumor cells, too, so that the drug, fatally enough, also promotes their growth.
Which effect will ultimately be stronger in a treatment with EPO is determined by a multitude of factors which mutually impact each other. The resulting complexity can best be captured by a systems biology approach, which processes data from experimental research in mathematical models. Scientists in the group of Prof. Dr. Ursula Klingmüller from DKFZ are networking in the “LungSys II" consortium in an effort to use systems biology to make the treatment of lung cancer patients with erythropoietin safer.